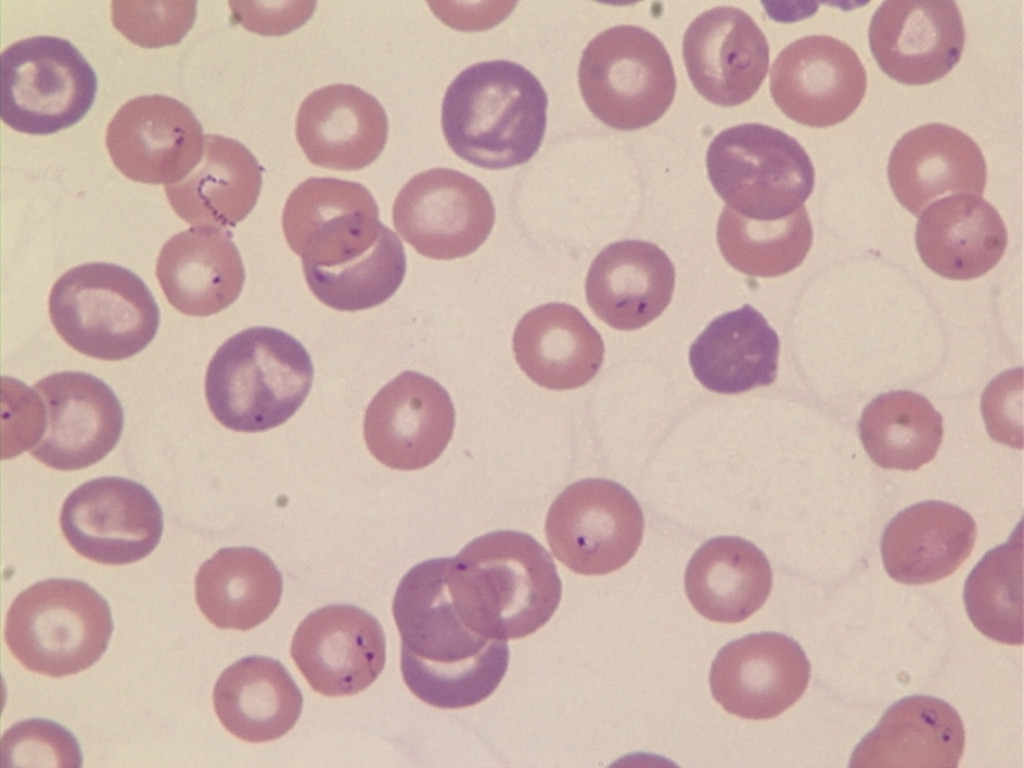
犬巴贝斯焦虫病

犬焦虫病症状

犬巴贝斯焦虫病
图片尺寸1024x768
病例分享 | 一例小焦虫感染引起犬溶血致严重贫血的病例
图片尺寸967x643
狗狗焦虫病 - 新手训练 - 猛犬俱乐部-中国具有影响力的猛犬网站
图片尺寸780x1052
被焦虫病狗狗挠了一下,会传染吗
图片尺寸1280x960
讨论我家狗狗得了巴贝斯虫病焦虫病想请教一下大家
图片尺寸1080x810
焦虫
图片尺寸922x1407
犬巴贝斯虫焦虫病的检测方法
图片尺寸534x703
狗得焦虫病是怎么治疗?试试这几个办法
图片尺寸579x345
犬焦虫症的临床症状与检验技术
图片尺寸445x355
可恶的焦虫病,哪位前辈知道这是什么情况 - 比特犬 - 猛犬俱乐部-中国
图片尺寸1488x1984
看看我这条狗这个是贫血还是焦虫,除了尿黄,其余的都是好的 - 比特犬
图片尺寸1040x780
在我家宝宝确诊前真的没未听过焦虫病,得知后懊恼又自责,我知道是我
图片尺寸960x1280
狗狗焦虫病
图片尺寸1080x1439
我的狗狗得了焦虫病
图片尺寸1000x1333
可恶的焦虫病,哪位前辈知道这是什么情况 - 比特犬 - 猛犬俱乐部-中国
图片尺寸1488x1984
请问狗狗这是怎么了?
图片尺寸677x906
老年狗狗焦虫病复发怎么办
图片尺寸887x1181
比熊犬巴贝斯虫病,小焦虫病
图片尺寸1080x810
一,犬焦虫症的常见症状一旦狗狗感染了焦虫病,一定会导致狗狗缺铁性
图片尺寸444x307
犬巴贝斯焦虫
图片尺寸1024x768